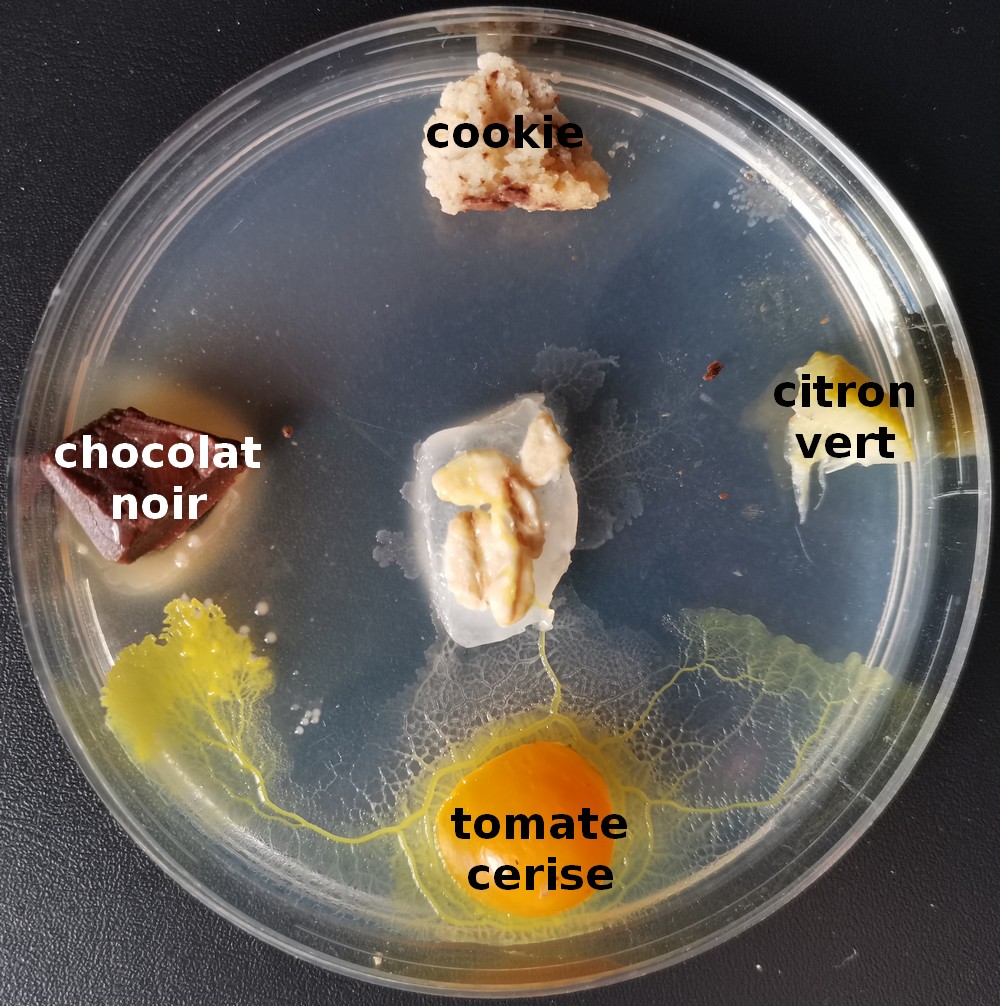
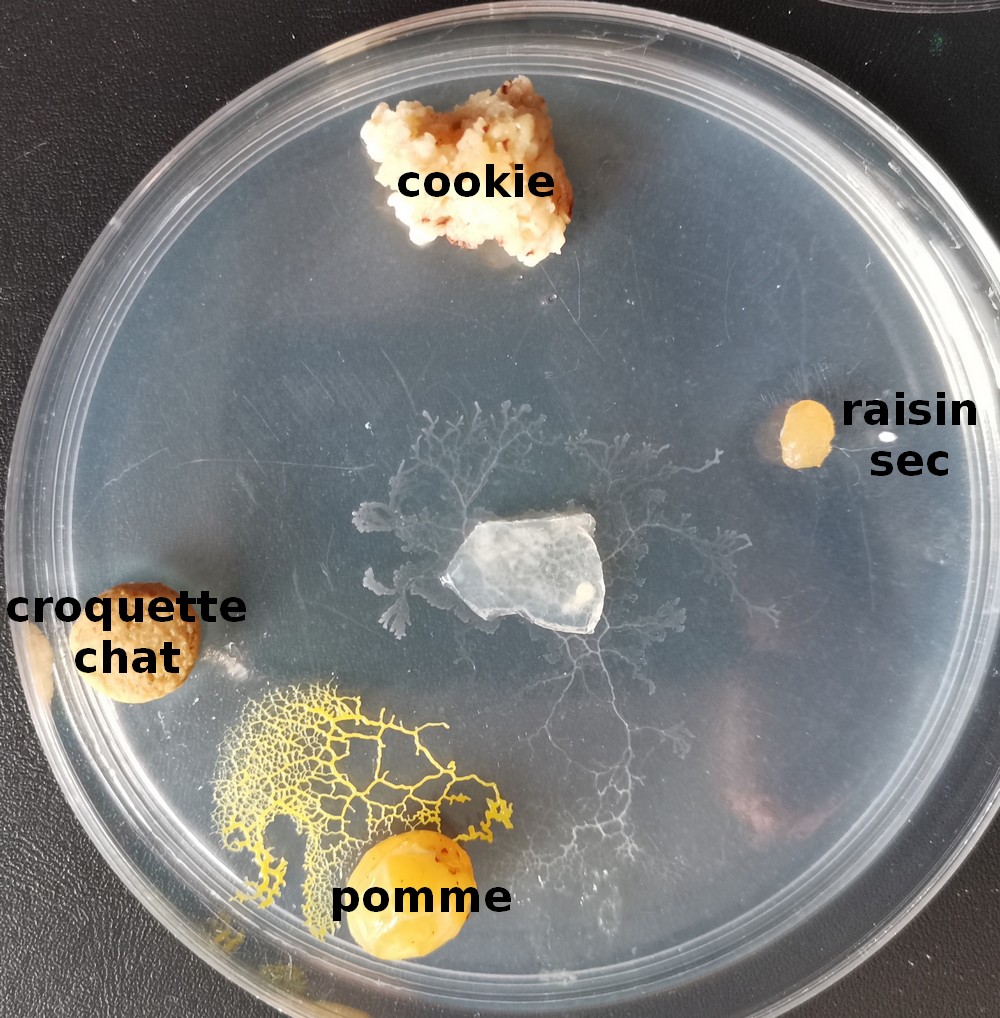

Nous allons étudier le goût des blobs. Pour cela chaque groupe va déposer un blob sur de la gélose au centre de la boite de Pétri. Puis nous mettrons 4 nourritures différentes et nous observerons les déplacements du blob après 2 jours. Rappel : le blob est visible en jaune, les traces blanchâtres sont le mucus que le blob a laissé quand il est passé.
Les blobs des CE1 après 2 jours
(Cliquez sur les images pour les agrandir)


Les blobs des CE2 après 2 jours

Laisser un commentaire